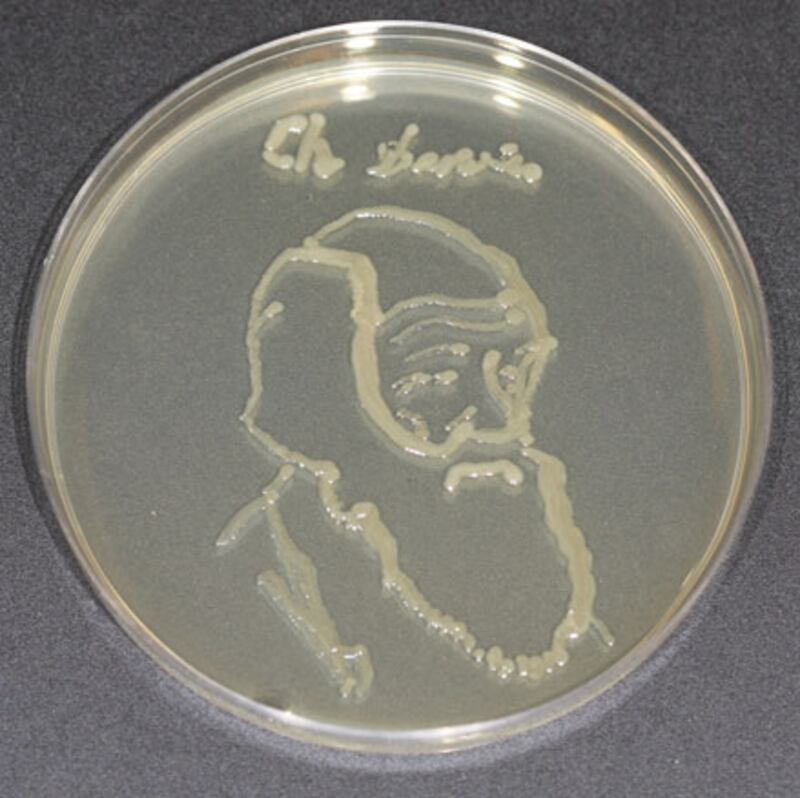
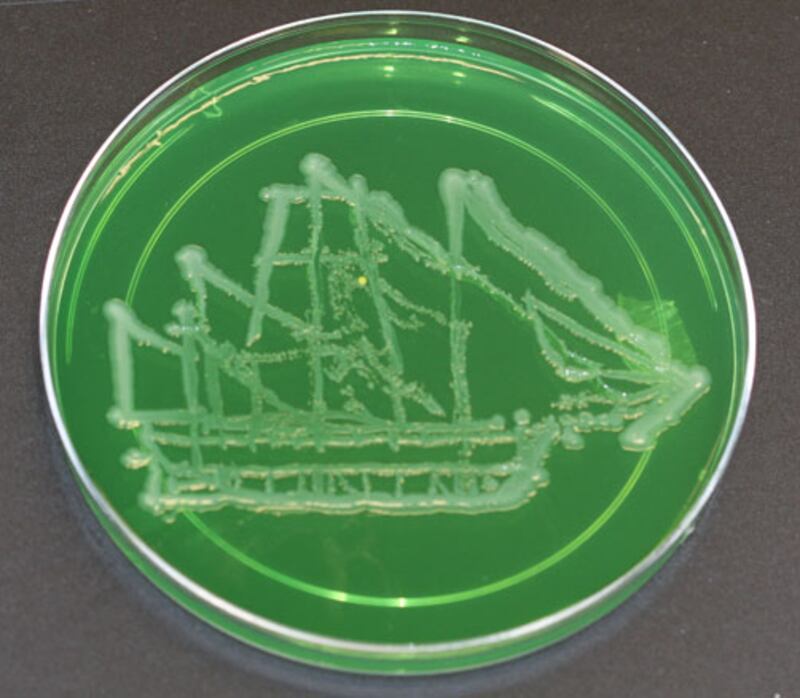
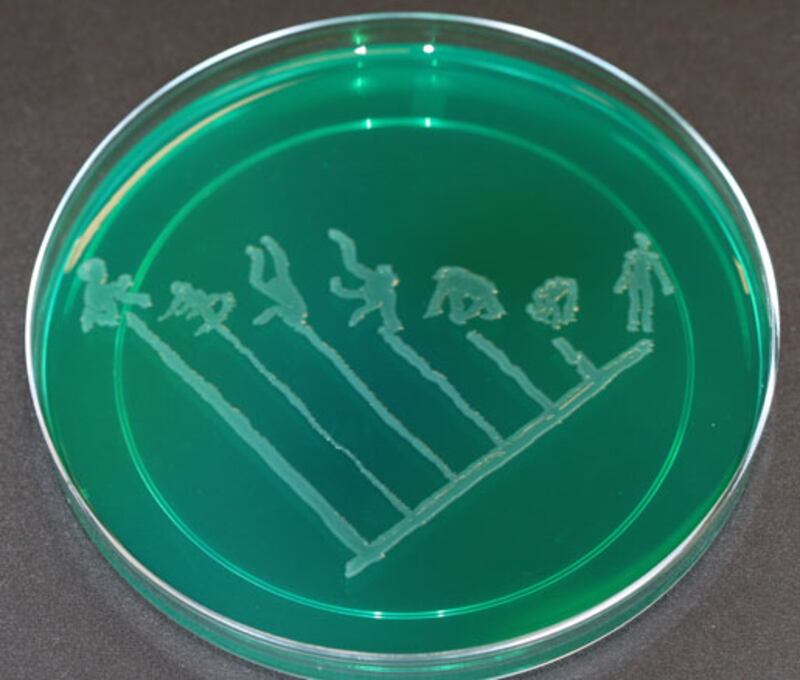

Edgar Lissel's first microbial artwork featuring a destroyed WW2 submarine bunker in the German harbor town of Kiel. "The ephemeral and vanishing character of the bunker was mirrored in the creation of the image through the bacteria,” Lissel explains. "Both the original and the image exist only in the reproduction. The bunker was completely destroyed soon after. The bacteria-image could only be kept through the photography.”
After failed attempts with toothpicks, Dr. T. Ryan Gregory finally settled on using a small paintbrush and E. coli in a liquid medium to create his portrait of Charles Darwin on colored agar. The portrait was part of his This View of Life exhibit at Canada's University of Guelph in honor of the 200th anniversary of Charles Darwin's birth and the 150th anniversary of the publication of On the Origin of Species.

British photography lecturer Susan Boafo created a series called Endless Forms Most Beautiful with millions of aquatic microorganisms that swam toward light passing through stencils. As the microbes moved toward the light, they projected the image of the stencil, capturing the process of carrying out photosynthesis.
Dr. T. Ryan Gregory and his lab painted with E. coli to create this rendering of the HMS Beagle on colored agar as part of his This View of Life exhibit at Canada's University of Guelph.
Gregory and his fellow lab masterminds created this depiction of the primate tree and the evolution from apes to humans as part of his This View of Life exhibit to celebrate Darwin.

Dr. Jeff Tabor created a bacterial image of Einstein by projecting light onto film made of genetically engineered E. coli in 2007. The postdoctoral fellow at the University of California has continued to work with bacteria and light and won a prize at the 2009 International Genetically Engineered Machine competition for his team's rudimentary E. coli camera.

Tabor's associate, Aaron Chevalier, a graduate student in Biomedical Engineering at the University of Texas at Austin, helped develop the light projection technology used to produce the bacterial photograph of Einstein, and this one of science's rock star, Charles Darwin.

